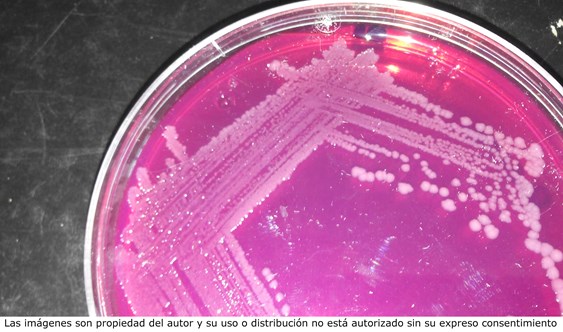

¿Por qué debemos de iniciar ya el control de la salmonelosis porcina en las explotaciones? / Raúl Carlos Mainar

Fecha: 20-Apr-2020
Tags: Salmonella , porcino , industria carnica
Raúl Carlos Mainar
Departamento de Patologia Animal
![]() Facultad de Veterinaria - Universidad de Zaragoza
Facultad de Veterinaria - Universidad de Zaragoza
Instituto Agroalimentario de Aragón (IA2)
rcmainar@unizar.es
Antes de responder a esa pregunta tenemos que tener claro si es necesario controlar una infección que produce muy pocas pérdidas económicas en la explotación. Es decir, conocer su “para qué”. Buscar el “para qué” de algo, me contaron una vez, nos obliga a situarnos en el futuro para tratar de establecer el valor que tendrá la acción que se pretende realizar. Si no somos capaces de encontrarlo, difícilmente realizaremos ese examen crítico previo necesario para definir esos cambios que necesitaremos llevar a cabo.
Pero en este caso, buscar el “para qué” es más difícil de lo que pensaba cuando empecé a trabajar en este problema, hace ya muchos años. Pues, aunque debería ser fácil justificarlo en base a que sabemos que la salmonelosis es una infección de carácter zoonótico y la segunda toxiinfección alimentaria más importante en la UE, desafortunadamente esta idea suele “caer en saco roto”. Seguimos teniendo el convencimiento de que la salmonelosis es un problema principalmente asociado con las aves y sus productos derivados, y que nuestro papel en este problema es marginal. Así que creo que es mejor buscar el “para qué” en otro sitio.
Colonias de Salmonella en agar verde brillante
España se convirtió en 2015 en el país europeo con mayor censo porcino (4º del mundo). Producimos muchísima más carne de cerdo de la que somos capaces de consumir, por lo que nos hemos convertido también en uno de los principales países exportadores. Necesitamos vender a otros países, y exportamos a países europeos (Francia, Italia, Portugal, Reino Unido, Alemania, Polonia, etc.) y asiáticos (Corea del Sur, Filipinas, China, Japón, etc.).

El origen de la contaminación de las canales porcinas con Salmonella está en la llegada al matadero de cerdos infectados.
Algunos de los países europeos a los que exportamos iniciaron sus propios programas de control de la salmonelosis porcina hace unos años (Alemania -2002-, Reino Unido -2002-, Holanda -2005-, Bélgica -2005-). Si bien es verdad que el éxito de los mismos es bastante cuestionable, su implementación refleja una preocupación de estos países por reducir los niveles de esta infección en su cabaña porcina. Además, tanto estos, como los que todavía no han iniciado programas de control, son conscientes de la fotografía que nos sacó la EFSA en los diversos estudios que se realizaron entre 2006 y 2008 para determinar la situación de nuestro sector respecto a la salmonelosis porcina. Éramos los líderes europeos en prevalencia de infección por Salmonella en cerdos sacrificados en matadero (30%) y en explotaciones de madres (64%). Y, por los estudios que vamos haciendo, da la impresión que poco ha cambiado la situación desde entonces.
Respecto a los países asiáticos, aunque podríamos dudar en algunos casos de sus propios niveles de seguridad alimentaria, sin embargo, suelen ser muy exigentes en cuanto a los niveles sanitarios demandados a la hora de comprar carne en otros países. Y si no, que les pregunten a los mataderos y empresas cárnicas que exportan a esas zonas, que tienen que dedicar un esfuerzo continuo a la realización de auditorías de calidad para satisfacer las demandas de estos clientes.
La experiencia nos confirma que la presencia de Salmonella en las canales porcinas está relacionada con la infección en los animales que son sacrificados, bien de forma directa, al presentar la bacteria en el contenido intestinal del animal, o indirectamente por la contaminación ambiental que generan a partir de la excreción de Salmonella por las heces. Por todo ello creo que se justifica una actuación en las explotaciones. El objetivo no puede ser erradicar Salmonella de los cebaderos, hoy por hoy misión imposible, si no cambiar esa imagen que tienen de nosotros, reduciendo al menos a la media comunitaria (10%) la prevalencia global de la infección en los animales que van a matadero. Si decidimos empezar, tenemos la ventaja de poder analizar lo que otros países han hecho antes y aprender para no repetir errores.
En definitiva, nuestro “para qué” podría ser una cuestión de imagen al exterior. Si nos planteamos iniciar un programa nacional de control frente a la salmonelosis porcina, no hay duda de que cambiaremos la perspectiva que pueden tener de nosotros los países importadores de carne de cerdo. Eso podrá ser muy útil cuando la demanda del mercado exterior disminuya y haya que competir con países que hace tiempo iniciaron estos programas. Además, nos permitirá mejorar la sanidad general de los rebaños y la calidad sanitaria de la carne, reduciendo la probabilidad de transmisión de la infección a las personas. Como país, no solo seríamos ejemplo de productividad, sino también de calidad sanitaria.













